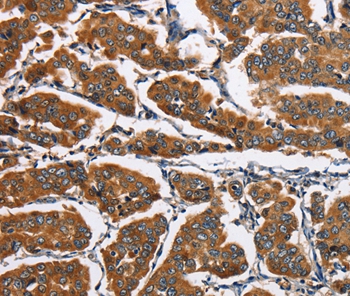

4E-BP2 / EIF4EBP2 Antibody
LS-C813214
ApplicationsWestern Blot, ELISA
Product group Antibodies
TargetEIF4EBP2
Overview
- SupplierLifeSpan BioSciences
- Product Name4E-BP2 / EIF4EBP2 Antibody
- Delivery Days Customer14
- Application Supplier NoteApplications should be user optimized.
- ApplicationsWestern Blot, ELISA
- Applications SupplierELISA (1:10000 - 1:20000), WB (1:500 - 1:2000) Applications should be user optimized.
- CertificationResearch Use Only
- ClonalityMonoclonal
- ConjugateUnconjugated
- Estimated Purity...
- Gene ID1979
- Target nameEIF4EBP2
- Target descriptioneukaryotic translation initiation factor 4E binding protein 2
- Target synonyms4EBP2; 4E-BP2; eIF4E-binding protein 2; eukaryotic translation initiation factor 4E-binding protein 2; PHASII; phosphorylated, heat and acid stable regulated by insulin protein II
- HostMouse
- IsotypeIgG1
- Storage Instruction-20°C
- UNSPSC12352203